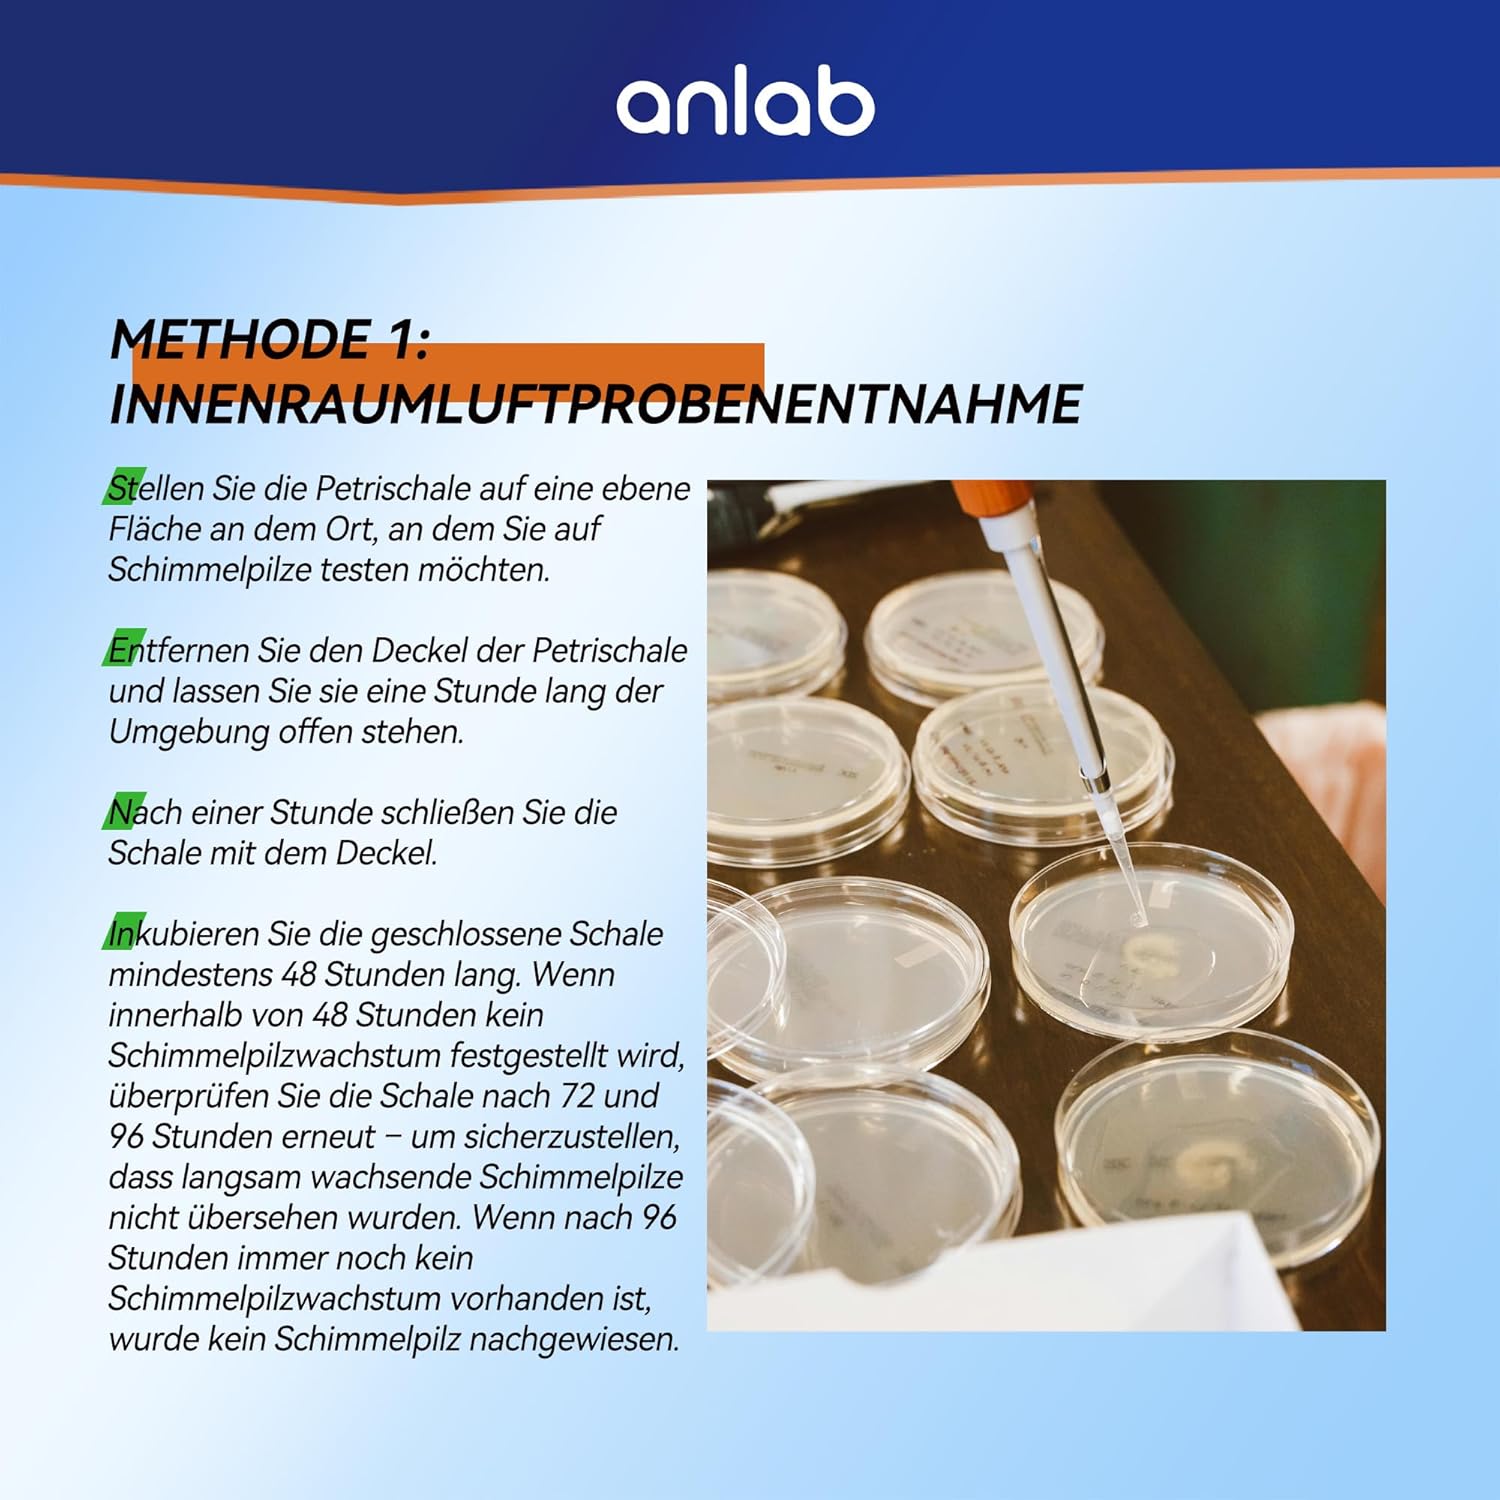

Mold Test Kit for Home – Do It Yourself Home Mold Detector | Test HVAC System | Home Surfaces | Indoor Air Quality Testing Kit – Identification Guide Included – Sealed Separately (Items of 6)
$56.99
Why we picked this
Product Details
The Mold Test Kit for Home is designed for easy, do-it-yourself mold detection. This kit allows you to test various surfaces in your home, including HVAC systems, to ensure your indoor air quality is safe. Each kit comes with an identification guide to help you interpret the results accurately. The plates are individually sealed to maintain their effectiveness until you're ready to use them.
- Tests for mold on surfaces and in the air.
- Includes an identification guide for easy result interpretation.
- Individually sealed plates for maximum reliability.
- Suitable for various areas in your home.
Pros & Cons
- Easy to use for home testing
- Comes with an identification guide
- Individually sealed for reliability
- Tests multiple surfaces and air quality
- May require multiple kits for larger homes
- Results may take time to process
- Not a substitute for professional mold remediation
$56.99